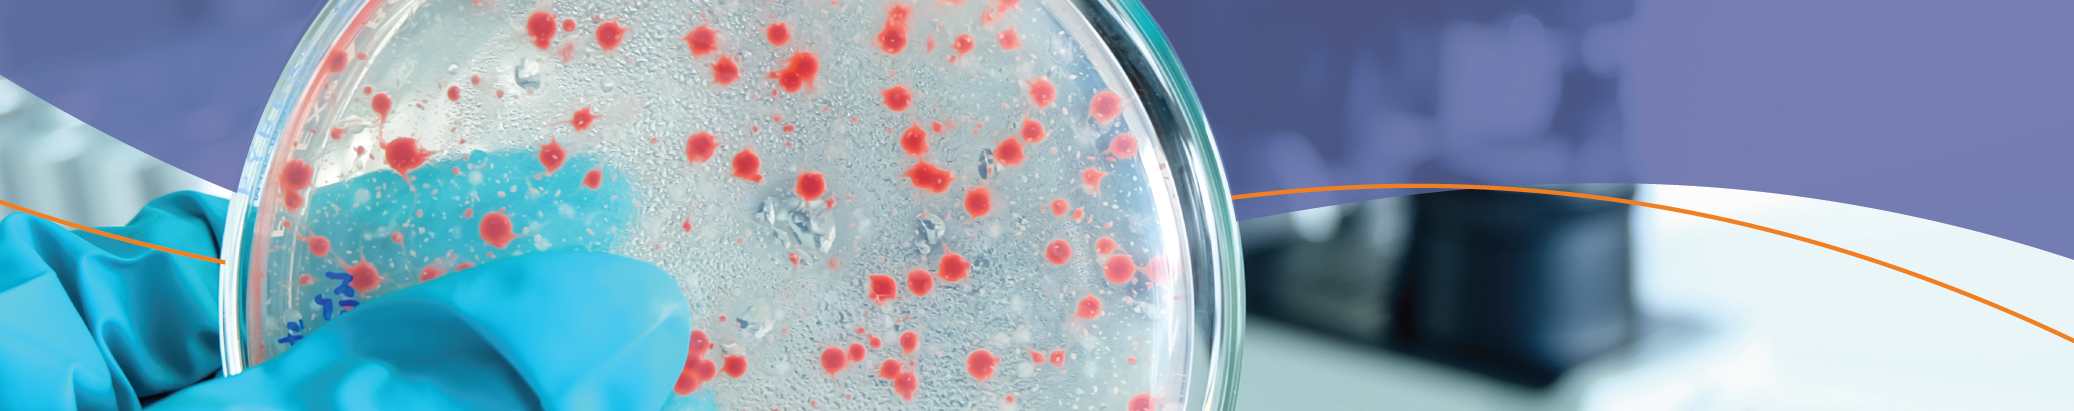

Search >>
Fungal Library
Contact UsSartorya sp
Scedosporium sp
Schizophyllum commune
Scolecobasidium sp
Scopulariopsis sp
Sepedonium sp
Septonema sp
Serpula lacrimans
Smuts
Sordaria sp
Spadicoides sp
Spegazzinia sp
Spiniger state of Heterobasidion species
Sporobolomyces sp
Sporormiella sp
Sporothrix sp
Sporotrichum sp
Stachybotrys sp
Stemphylium sp
Stephanosporium sp
Syncephalastrum racemosum